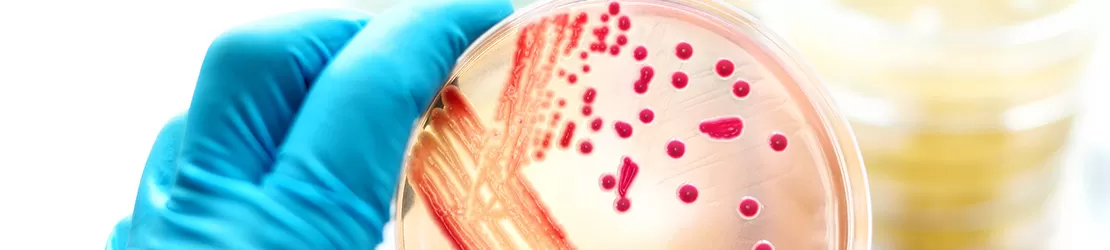
Cultura de bacterii cu potential de a cauza infectii si septicemie

Despre septicemie
Septicemia este o infecție gravă și generalizată care apare atunci când germenii – de obicei bacterii – pătrund în sânge și se răspândesc rapid în organism. Această stare reprezintă forma extremă de răspuns a organismului la infecție, denumită sepsis, și constituie o urgență medicală majoră, cu o rată a mortalității de până la 50%.
Dacă nu se intervine prompt, septicemia, sau otrăvirea sângelui, poate provoca leziuni severe ale țesuturilor, insuficiență multiplă de organe și chiar deces. Din acest motiv, recunoașterea rapidă a simptomelor și inițierea imediată a tratamentului sunt esențiale pentru a preveni complicațiile grave și pentru a crește șansele de supraviețuire.
Cauze
Sângele conține numeroase celule albe care protejează organismul împotriva bacteriilor și virusurilor. În mod normal, aceste celule reușesc să controleze și să elimine infecțiile. De exemplu, dacă o rană se infectează, celulele albe luptă împotriva bacteriilor și ajută la vindecarea țesutului.
Uneori, însă, infecția poate depăși capacitatea sistemului imunitar, fie pentru că este foarte severă, fie din cauza unui sistem imunitar slăbit de alte boli. Atunci germenii pot pătrunde în sânge și se pot răspândi rapid în tot corpul, afectând alte organe și provocând complicații grave.
În majoritatea cazurilor, cauzele septicemiei sunt corelate cu diferite tipuri de infecții, cum ar fi:
- infecții pulmonare (pneumonie);
- infecții ale tractului urinar;
- infecții dermatologice (răni infectate);
- infecții intestinale.
Germenii care se dezvoltă cel mai frecvent în sepsis sunt:
- Staphylococcus aureus (stafilococ);
- Escherichia coli (E. coli);
- unele tipuri de streptococ.
Factori de risc
Unele persoane sunt mai susceptibile la septicemie, inclusiv pacienții cu un sistem imunitar slăbit, persoanele în vârstă și copiii foarte mici. Septicemia la copii apare cu precădere înainte de împlinirea vârstei de un an. Persoanele cu afecțiuni medicale cronice, cum ar fi diabetul sau bolile de rinichi sunt, de asemenea, expuse unui risc mai mare de îmbolnăvire.
Alți factori de risc includ:
- operație recentă sau spitalizare;
- proceduri medicale invazive (dializa);
- traume sau răni;
- arsuri;
- consumul de droguri prin injectare;
- sistem imunitar slăbit din cauza chimioterapiei sau a altor medicamente.
Simptome
Simptomele septicemiei sau sepsisului pot să difere de la un pacient la altul. Cu toate acestea, cele mai comune semne ale acestei condiții medicale includ:
- erupție hemoragică (pete mici de sânge pe piele care pot să se mărească și să arate ca niște vânătăi recente, care se extind tot mai mult);
- lipsa poftei de mâncare;
- febră;
- ritm cardiac mai alert;
- greață și vărsături;
- disconfort sau dureri;
- sensibilitate la lumină;
- mâini și picioare reci.
Unii pacienți pot să se confrunte întâi cu simptome ale meningitei. Este esențial să te prezinți la un medic în cel mai scurt timp posibil pentru un diagnostic exact.
Diagnosticare
Diagnosticul de septicemie poate să implice investigații medicale realizate de mai mulți specialiști. De obicei, diagnosticarea se bazează pe o combinație de simptome clinice și analize de laborator.
Medicii trebuie să obțină cât mai multe informații legate de istoricul pacientului. În timpul examenului fizic, se va urmări detectarea semnelor vitale care indică un răspuns sistemic periculos. Aceste semne includ în mod tipic tensiunea arterială scăzută și o dereglare severă a temperaturii corpului, manifestată fie prin febră înaltă, fie, paradoxal și frecvent la vârstnici, prin hipotermie (temperatură scăzută). În paralel, se caută sursa infecției primare care a declanșat sepsisul, verificând semnele unor afecțiuni precum pneumonia, infecțiile urinare, celulita sau meningita.
Cu ajutorul analizelor de sânge se verifică prezența bacteriilor sau a altor microorganisme în sânge, evaluându-se, simultan, modul în care funcționează organele și numărul de celule sanguine.
Alte teste care pot fi utilizate pentru a ajuta la diagnosticarea septicemiei sunt investigațiile imagistice, cum ar fi razele X sau tomografiile, precum și probele de urină sau de spută, pentru a depista infecții în alte părți ale corpului.
Diagnosticul precoce este esențial, deoarece tratamentul prompt și monitorizarea atentă pot preveni complicațiile severe, inclusiv leziunile permanente ale organelor sau insuficiența multiplă de organe. În plus, recunoașterea timpurie a factorilor de risc, precum afecțiuni cronice sau imunitate scăzută, ajută medicii buni de la MedLife să adopte măsuri preventive și să reducă riscul de deces asociat septicemiei.
Tratament
În cazul în care un pacient este diagnosticat cu septicemie, medicul poate recomanda internarea în secția de ATI (terapie intensivă) pentru a opri răspândirea infecției în corp și pentru a menține organele în funcțiune. Perfuziile și oxigenul suplimentar sunt de ajutor în acest sens.
Antibioticele pot fi utile în lupta cu infecțiile cauzate de bacterii. Tratamentul inițial se bazează, în general, pe antibiotice cu spectru larg, care acționează împotriva unui număr mare de bacterii simultan. Dacă se reușește identificarea bacteriei specifice, medicul poate schimba tratamentul cu un antibiotic mai țintit, adaptat acelui agent patogen.
În cazul în care un pacient este în stare gravă, poate fi necesară ventilația sau dializa renală, precum și intervenții chirurgicale pentru drenarea sau curățarea unor infecții.
În general, tratamentul pentru septicemie diferă în funcție de simptomatologie și de gravitatea cazului.
Complicații
Unele complicații cauzate de septicemie pot include:
- insuficiență renală;
- țesut mort (cangrenă) pe degetele de la mâini și de la picioare, amputare;
- leziuni ale plămânilor, creierului sau inimii;
- un risc mai mare de infecții în timp.
Prevenție
Pentru a preveni intoxicarea sângelui (septicemia) este necesar să eviți infecțiile de orice tip. În acest sens, trebuie să ai grijă sporită la igienă și să urmezi câțiva pași de bază:
- spală mâinile cu apă și săpun în mod frecvent;
- monitorizează și controlează afecțiunile cronice de sănătate;
- curăță pielea imediat după rănirea de orice tip;
- păstrează rănile curate și urmărește semnele de infecție;
- apelează la medic dacă o infecție se agravează în ciuda aplicării tratamentului.
Întrebări frecvente despre septicemie
De la ce provine infecția în sânge?
Septicemia este cauzată de obicei de o infecție bacteriană care nu a putut fi controlată local de sistemul imunitar. Infecțiile inițiale se dezvoltă cel mai adesea în plămâni (pneumonie), în tractul urinar sau la nivelul rănilor și pielii. Germenii precum Staphylococcus aureus și Escherichia coli sunt printre cei mai frecvenți agenți patogeni implicați.
Septicemia este contagioasă?
Nu, septicemia sau infecția sângelui în sine nu este contagioasă. Ea nu se transmite direct de la o persoană la alta, deoarece este rezultatul răspândirii unei infecții existente în organism prin sânge. Totuși, infecțiile care pot provoca septicemie, precum pneumonia sau infecțiile urinare, pot fi contagioase în anumite condiții.
Ce simptome ai când ai septicemie?
Simptomele septicemiei pot să apară rapid și variază de la o persoană la alta. Cele mai frecvente includ febră sau temperatură scăzută, frisoane, ritm cardiac accelerat, respirație rapidă, confuzie, slăbiciune extremă, greață și vărsături. De asemenea, pot apărea pete roșii sau vânătăi pe piele, mâini și picioare reci sau dureri și disconfort general. La copii și vârstnici, simptomele pot fi mai subtile, de aceea este importantă intervenția medicală imediată.
Se poate trata septicemia?
Da. Dacă este depistată din timp, septicemia poate fi tratată. Intervenția rapidă crește considerabil șansele de recuperare
Cât timp poți trăi cu septicemie?
Șansele de supraviețuire în cazul septicemiei depind foarte mult de gravitatea infecției și de cât de rapid este început tratamentul. Dacă este diagnosticată și tratată la timp, multe persoane se recuperează complet, deși pot rămâne cu unele leziuni ale organelor. În lipsa tratamentului prompt, septicemia poate progresa rapid, putând pune viața în pericol în câteva ore sau zile. Factori precum vârsta, starea sistemului imunitar și prezența altor boli cronice influențează semnificativ prognosticul.
Bibliografie
- “Septicemia.” Hopkinsmedicine.org, 19 Nov. 2019, www.hopkinsmedicine.org
- “Sepsis.” Centers for Disease Control and Prevention, 29 Aug. 2022, www.cdc.gov
- Forrester, Joseph D. “Sepsis and Septic Shock.” Merck Manuals Professional Edition, Merck Manuals, 8 Mar. 2023, www.merckmanuals.com
- O’Connell, Krista. „Septicemia”, Healthline, 2018, www.healthline.com/health/septicemia.
- „Septicemia (Blood Poisoning): Causes, Management”, Cleveland Clinic, 2023, my.clevelandclinic.org/health/diseases/21539-septicemia.
Echipa medicală - Boli infectioase
Solicită o programare
Alege opțiunea de a te programa online, simplu și rapid, prin intermediul formularului de programare.